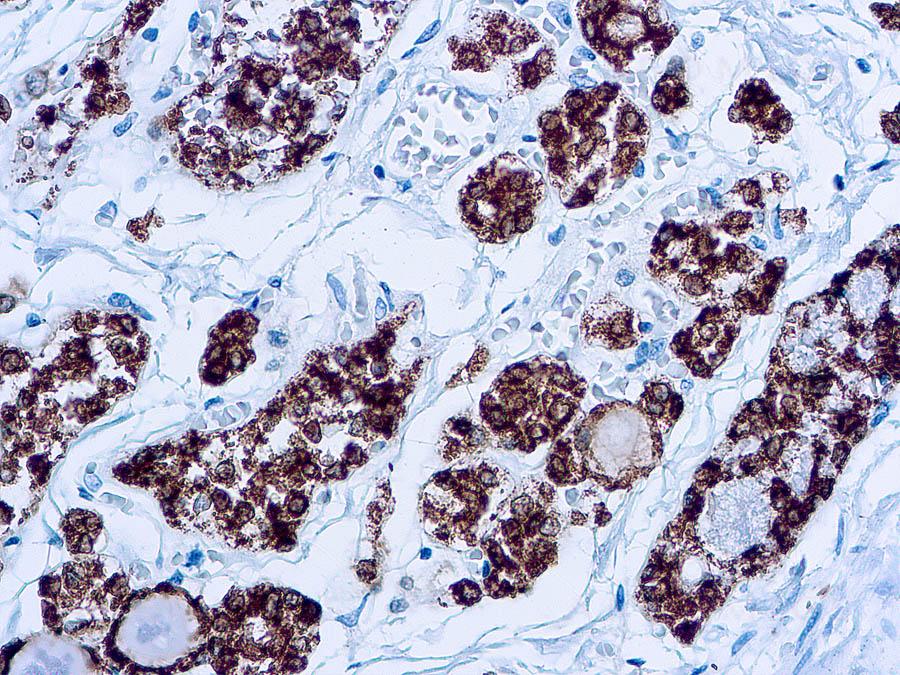

Mouse Monoclonal Antibody to Thyroid Peroxidase(Clone: MoAb47)(Discontinued)
Figure 1 : Formalin fixed paraffin embedded human thyroid stained with thyroid peroxidase antibody ( 10-11557).
Roll over image to zoom in

Shipping Info:
For estimated delivery dates, please contact us at [email protected]
Format : | T.C. Sup. |
Amount : | 0.5 ml |
Isotype : | Mouse IgG1 |
Content : | This antibody is supplied as tissue culture supernatant containing sodium azide as preservative. |
Storage condition : | Store at 2-8°C. |
Thyroid peroxidase (TPO) is a transmembrane protein of 107kDa containing a heme prosthetic group. It is present as a dimer on the apical surface of thyroid follicular cells. TPO is the primary enzyme involved in thyroid hormone synthesis. Malignant thyroid tumors exhibit an anomaly in TPO resulting in lower affinity for anti-TPO. This antibody may aid in the differentiation between benign and malignant thyroid tumors.
IHC : 1:10-1:25
For Research Use Only. Not for use in diagnostic/therapeutics procedures.
Subcellular location: | Cell surface |
Post transnational modification: | Cleaved in its N-terminal part. |
There are currently no product reviews
|